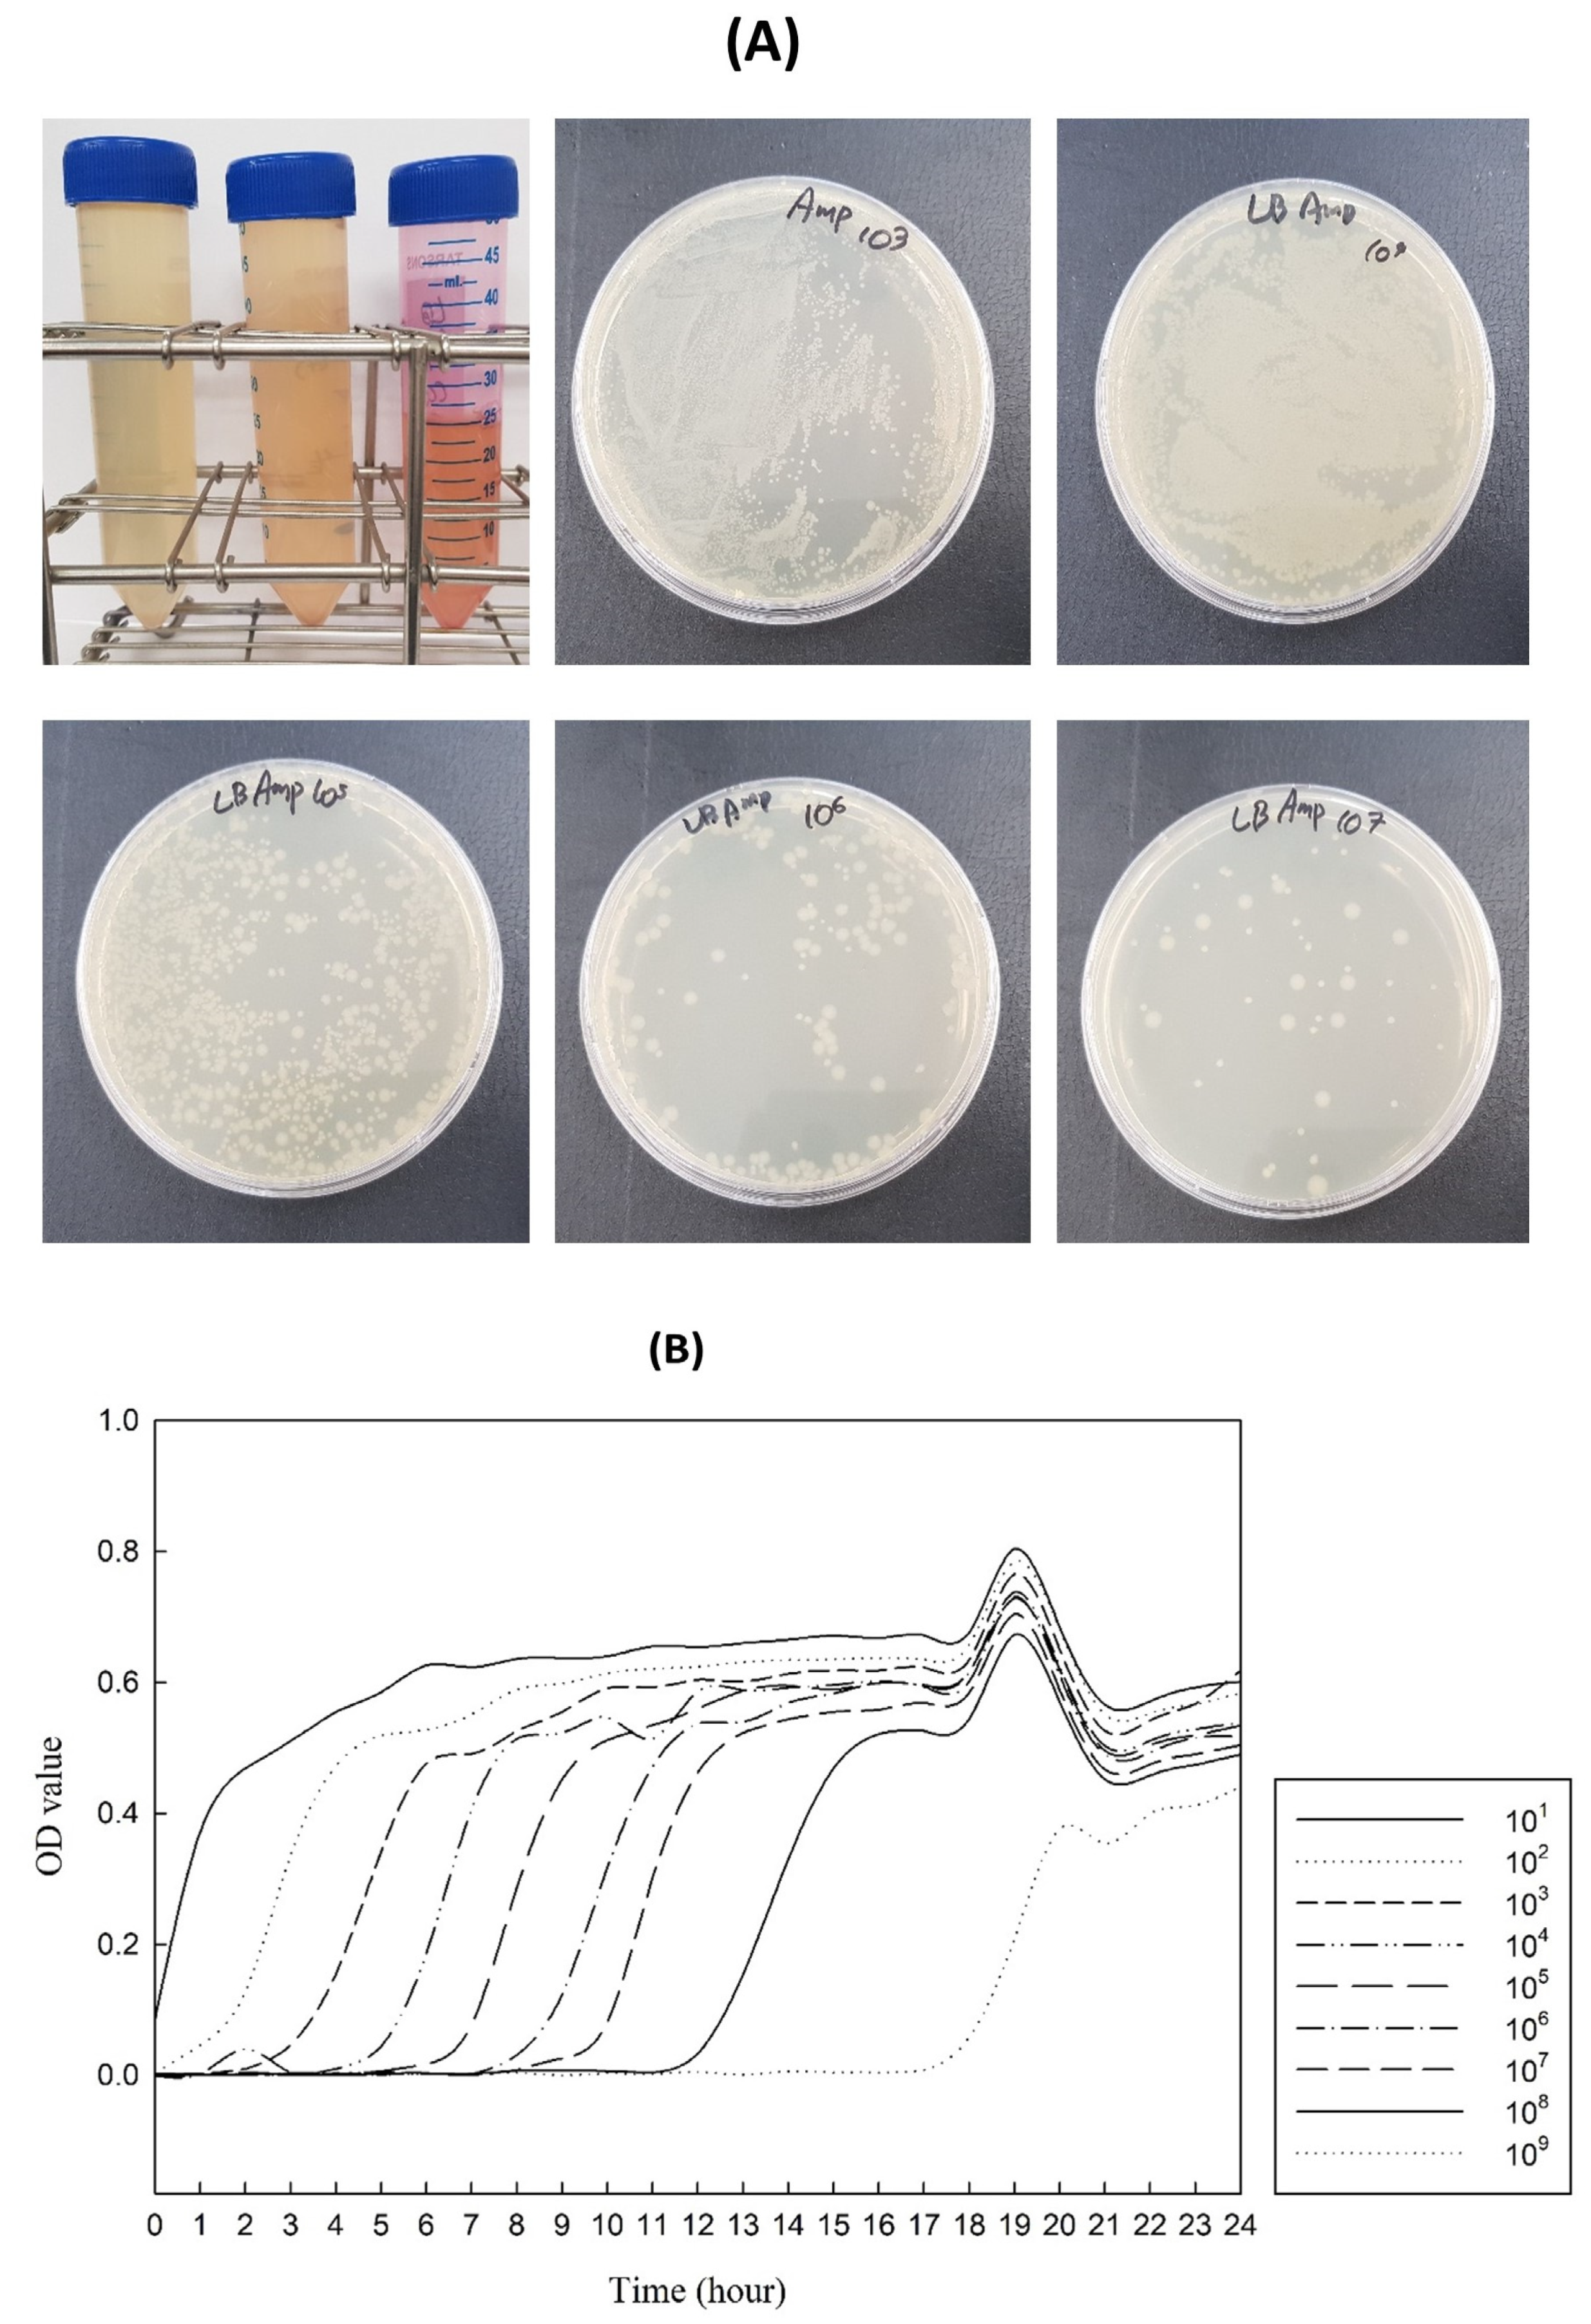
Foods 12 01281 g005 Foods 12 01281 g005

Production and Analytical Aspects of Natural Pigments to Enhance Alternative Meat Product Color
Abstract
1. Introduction
2. Materials and Methods
2.1. Chemicals, Biological Agents, and Instruments
2.1.1. Chemicals
2.1.2. Biological Agents
2.1.3. Instruments
2.2. Chemical Structure and Extraction of Anthocyanins
2.3. Chemical Structure and Extraction of Chlorophyll
Synthesis of Fe-Pheophytin by Ion Exchange Chromatography
2.4. Leghemoglobin
2.4.1. Plasmid
2.4.2. Microbial Culture
2.5. Electrophoresis
2.6. Color Measurement
2.7. Absorbance Measurement
2.8. High-Performance Liquid Chromatography (HPLC) Analysis
2.9. Statistical Analysis
3. Results and Discussion
3.1. Anthocyanin
High-Performance Liquid Chromatography
3.2. Chlorophyll and Fe-Pheophytin
3.3. Leghaemoglobin
3.3.1. Microbial Culture
3.3.2. SDS-PAGE
3.4. Color Measurements Pigments
3.5. Absorbance Level
4. Conclusions
Author Contributions
Funding
Data Availability Statement
Conflicts of Interest
References
- Bakhsh, A.; Lee, S.-J.; Lee, E.-Y.; Hwang, Y.-H.; Joo, S.-T. Traditional plant-based meat alternatives, current, and future perspective: A review. J. Agric. Life Sci. 2021, 55, 1–10. [Google Scholar] [CrossRef]
- Bakhsh, A.; Lee, E.-Y.; Ncho, C.M.; Kim, C.-J.; Son, Y.-M.; Hwang, Y.-H.; Joo, S.-T. Quality Characteristics of Meat Analogs through the Incorporation of Textured Vegetable Protein: A Systematic Review. Foods 2022, 11, 1242. [Google Scholar] [CrossRef] [PubMed]
- Bohrer, B.M. An investigation of the formulation and nutritional composition of modern meat analogue products. Food Sci. Hum. Wellness 2019, 8, 320–329. [Google Scholar] [CrossRef]
- Ahmad, M.; Hirz, M.; Pichler, H.; Schwab, H. Protein expression in Pichia pastoris: Recent achievements and perspectives for heterologous protein production. Appl. Microbiol. Biotechnol. 2014, 98, 5301–5317. [Google Scholar] [CrossRef]
- Kumar, P.; Chatli, M.; Mehta, N.; Singh, P.; Malav, O.; Verma, A.K. Meat analogues: Health promising sustainable meat substitutes. Crit. Rev. Food Sci. Nutr. 2017, 57, 923–932. [Google Scholar] [CrossRef]
- Sakai, K.; Sato, Y.; Okada, M.; Yamaguchi, S. Synergistic effects of laccase and pectin on the color changes and functional properties of meat analogs containing beet red pigment. Sci. Rep. 2022, 12, 1168. [Google Scholar] [CrossRef] [PubMed]
- Sakai, K.; Sato, Y.; Okada, M.; Yamaguchi, S. Improved functional properties of meat analogs by laccase catalyzed protein and pectin crosslinks. Sci. Rep. 2021, 11, 1–10. [Google Scholar] [CrossRef] [PubMed]
- Godfray, H.C.J.; Aveyard, P.; Garnett, T.; Hall, J.W.; Key, T.J.; Lorimer, J.; Pierrehumbert, R.T.; Scarborough, P.; Springmann, M.; Jebb, S.A. Meat consumption, health, and the environment. Science 2018, 361, eaam5324. [Google Scholar] [CrossRef]
- Fehér, A.; Gazdecki, M.; Véha, M.; Szakály, M.; Szakály, Z. A Comprehensive Review of the Benefits of and the Barriers to the Switch to a Plant-Based Diet. Sustainability 2020, 12, 4136. [Google Scholar] [CrossRef]
- Sakai, K.; Sato, Y.; Okada, M.; Yamaguchi, S. Cyclodextrins produced by cyclodextrin glucanotransferase mask beany off-flavors in plant-based meat analogs. PLoS ONE 2022, 17, e0269278. [Google Scholar] [CrossRef]
- Sakai, K.; Okada, M.; Yamaguchi, S. Decolorization and detoxication of plant-based proteins using hydrogen peroxide and catalase. Sci. Rep. 2022, 12, 22432. [Google Scholar] [CrossRef] [PubMed]
- He, J.; Evans, N.M.; Liu, H.; Shao, S. A review of research on plant-based meat alternatives: Driving forces, history, manufacturing, and consumer attitudes. Compr. Rev. Food Sci. Food Saf. 2020, 19, 2639–2656. [Google Scholar] [CrossRef] [PubMed]
- Luzardo-Ocampo, I.; Ramírez-Jiménez, A.K.; Yañez, J.; Mojica, L.; Luna-Vital, D.A. Technological applications of natural colorants in food systems: A review. Foods 2021, 10, 634. [Google Scholar] [CrossRef] [PubMed]
- Manzoor, M.; Singh, J.; Gani, A.; Noor, N. Valorization of natural colors as health-promoting bioactive compounds: Phytochemical profile, extraction techniques, and pharmacological perspectives. Food Chem. 2021, 362, 130141. [Google Scholar] [CrossRef]
- Albuquerque, B.R.; Pinela, J.; Barros, L.; Oliveira, M.B.P.; Ferreira, I.C. Anthocyanin-rich extract of jabuticaba epicarp as a natural colorant: Optimization of heat-and ultrasound-assisted extractions and application in a bakery product. Food Chem. 2020, 316, 126364. [Google Scholar] [CrossRef]
- Cortez, R.; Luna-Vital, D.A.; Margulis, D.; Gonzalez de Mejia, E. Natural pigments: Stabilization methods of anthocyanins for food applications. Compr. Rev. Food Sci. Food Saf. 2017, 16, 180–198. [Google Scholar] [CrossRef] [PubMed]
- Selig, M.J.; Gamaleldin, S.; Celli, G.B.; Marchuk, M.A.; Smilgies, D.-M.; Abbaspourrad, A. The stabilization of food grade copper-chlorophyllin in low pH solutions through association with anionic polysaccharides. Food Hydrocoll. 2020, 98, 105255. [Google Scholar] [CrossRef]
- Ghosh, S.; Sarkar, T.; Das, A.; Chakraborty, R. Natural colorants from plant pigments and their encapsulation: An emerging window for the food industry. LWT 2022, 153, 112527. [Google Scholar] [CrossRef]
- Bakhsh, A.; Lee, E.-Y.; Bakry, A.M.; Rathnayake, D.; Son, Y.-M.; Kim, S.-W.; Hwang, Y.-H.; Joo, S.-T. Synergistic effect of lactoferrin and red yeast rice on the quality characteristics of novel plant-based meat analog patties. LWT 2022, 171, 114095. [Google Scholar] [CrossRef]
- Takeoka, G.; Dao, L. Anthocyanins In Methods of Analysis for Functional Foods and Nutraceuticals; CRC Press: Boca Raton, FL, USA, 2002. [Google Scholar]
- Wrolstad, R.E.; Culver, C.A. Alternatives to those artificial FD&C food colorants. Annu. Rev. Food Sci. Technol. 2012, 3, 59–77. [Google Scholar]
- He, J.; Giusti, M.M. Anthocyanins: Natural colorants with health-promoting properties. Annu. Rev. Food Sci. Technol. 2010, 1, 163–187. [Google Scholar] [CrossRef]
- Wu, X.; Beecher, G.R.; Holden, J.M.; Haytowitz, D.B.; Gebhardt, S.E.; Prior, R.L. Concentrations of anthocyanins in common foods in the United States and estimation of normal consumption. J. Agric. Food Chem. 2006, 54, 4069–4075. [Google Scholar] [CrossRef] [PubMed]
- FAO Joint; World Health Organization; WHO Expert Committee on Food Additives. Evaluation of Certain Contaminants in Food: Eighty-Third Report of the Joint FAO/WHO Expert Committee on Food Additives; World Health Organization: Geneva, Switzerland, 2017. [Google Scholar]
- Garzón, G.; Wrolstad, R. The stability of pelargonidin-based anthocyanins at varying water activity. Food Chem. 2001, 75, 185–196. [Google Scholar] [CrossRef]
- Amr, A.; Al-Tamimi, E. Stability of the crude extracts of Ranunculus asiaticus anthocyanins and their use as food colourants. Int. J. Food Sci. Technol. 2007, 42, 985–991. [Google Scholar] [CrossRef]
- Ghosh, D.; Konishi, T. Anthocyanins and anthocyanin-rich extracts: Role in diabetes and eye function. Asia Pac. J. Clin. Nutr. 2007, 16, 200–208. [Google Scholar]
- Tsuda, T. Regulation of adipocyte function by anthocyanins; possibility of preventing the metabolic syndrome. J. Agric. Food Chem. 2008, 56, 642–646. [Google Scholar] [CrossRef] [PubMed]
- Nelson, R.; Ferruzzi, M. Synthesis and Bioaccessibility of Fe-Pheophytin Derivatives from Crude Spinach Extract. J. Food Sci. 2008, 73, H86–H91. [Google Scholar] [CrossRef]
- Hsu, C.-Y.; Chao, P.-Y.; Hu, S.-P.; Yang, C.-M. The antioxidant and free radical scavenging activities of chlorophylls and pheophytins. Food Nutr. Sci. 2013, 4, 8. [Google Scholar] [CrossRef]
- No, J.; Yoon, H.; Park, S.; Yoo, S.J.; Shin, M. Color stability of chlorophyll in young barley leaf. J. East Asian Soc. Diet. Life 2016, 26, 314–324. [Google Scholar]
- Fraser, R.Z.; Shitut, M.; Agrawal, P.; Mendes, O.; Klapholz, S. Safety evaluation of soy leghemoglobin protein preparation derived from Pichia pastoris, intended for use as a flavor catalyst in plant-based meat. Int. J. Toxicol. 2018, 37, 241–262. [Google Scholar] [CrossRef]
- Prabhu, K.; Bhute, A.S. Plant based natural dyes and mordants: A Review. J. Nat. Prod. Plant Resour. 2012, 2, 649–664. [Google Scholar]
- Pappas, V.M.; Athanasiadis, V.; Palaiogiannis, D.; Poulianiti, K.; Bozinou, E.; Lalas, S.I.; Makris, D.P. Pressurized Liquid Extraction of Polyphenols and Anthocyanins from Saffron Processing Waste with Aqueous Organic Acid Solutions: Comparison with Stirred-Tank and Ultrasound-Assisted Techniques. Sustainability 2021, 13, 12578. [Google Scholar] [CrossRef]
- Chávez-Santoscoy, R.A.; Lazo-Vélez, M.A.; Serna-Sáldivar, S.O.; Gutiérrez-Uribe, J.A. Delivery of flavonoids and saponins from black bean (Phaseolus vulgaris) seed coats incorporated into whole wheat bread. Int. J. Mol. Sci. 2016, 17, 222. [Google Scholar] [CrossRef] [PubMed]
- Heravi, E.J.; Aghdam, H.H.; Puig, D. Classification of Foods Using Spatial Pyramid Convolutional Neural Network. In Proceedings of the 19th International Conference of the Catalan Association for Artificial Intelligence, Barcelona, Catalonia, Spain, 19–21 October 2016; pp. 163–168. [Google Scholar]
- Moustafa, Y.M.; Morsi, R.E. Ion exchange chromatography-An overview. Column Chromatogr. 2013, 1, 1–30. [Google Scholar]
- Tran, L.; Rathinasamy, V.A.; Beddoe, T. Development of a loop-mediated isothermal amplification assay for detection of Austropeplea tomentosa from environmental water samples. Anim. Dis. 2022, 2, 1–14. [Google Scholar] [CrossRef]
- Food and Drug Administration USA. Impossible Foods, Inc.; Filing of Color Additive Petition. Available online: https://www.federalregister.gov/documents/2018/12/13/2018-26949/impossible-foods-inc-filing-of-color-additive-petition (accessed on 15 March 2023).
- De Boer, A.; Krul, L.; Fehr, M.; Geurts, L.; Kramer, N.; Urbieta, M.T.; Van Der Harst, J.; Van De Water, B.; Venema, K.; Schütte, K. Animal-free strategies in food safety & nutrition: What are we waiting for? Part I: Food safety. Trends Food Sci. Technol. 2020, 106, 469–484. [Google Scholar]
- Jin, Y.; He, X.; Andoh-Kumi, K.; Fraser, R.Z.; Lu, M.; Goodman, R.E. Evaluating potential risks of food allergy and toxicity of soy leghemoglobin expressed in Pichia pastoris. Mol. Nutr. Food Res. 2018, 62, 1700297. [Google Scholar] [CrossRef]
- Bakhsh, A.; Lee, S.-J.; Lee, E.-Y.; Hwang, Y.-H.; Joo, S.-T. Characteristics of Beef Patties Substituted by Different Levels of Textured Vegetable Protein and Taste Traits Assessed by Electronic Tongue System. Foods 2021, 10, 2811. [Google Scholar] [CrossRef]
- Ismail, I.; Hwang, Y.-H.; Bakhsh, A.; Joo, S.-T. The alternative approach of low temperature-long time cooking on bovine semitendinosus meat quality. Asian-Australas. J. Anim. Sci. 2019, 32, 282. [Google Scholar] [CrossRef]
- Bakhsh, A.; Lee, S.-J.; Lee, E.-Y.; Sabikun, N.; Hwang, Y.-H.; Joo, S.-T. A Novel Approach for Tuning the Physicochemical, Textural, and Sensory Characteristics of Plant-Based Meat Analogs with Different Levels of Methylcellulose Concentration. Foods 2021, 10, 560. [Google Scholar] [CrossRef]
- Fernández-López, J.A.; Angosto, J.M.; Giménez, P.J.; León, G. Thermal stability of selected natural red extracts used as food colorants. Plant Foods Hum. Nutr. 2013, 68, 11–17. [Google Scholar] [CrossRef] [PubMed]
- Sabikun, N.; Bakhsh, A.; Rahman, M.S.; Hwang, Y.-H.; Joo, S.-T. Volatile and nonvolatile taste compounds and their correlation with umami and flavor characteristics of chicken nuggets added with milkfat and potato mash. Food Chem. 2021, 343, 128499. [Google Scholar] [CrossRef]
- Crozier, A.; Jaganath, I.B.; Clifford, M.N. Phenols, polyphenols and tannins: An overview. Plant Second. Metab. Occur. Struct. Role Hum. Diet 2006, 1, 1–25. [Google Scholar]
- Lianza, M.; Marincich, L.; Antognoni, F. The Greening of Anthocyanins: Eco-Friendly Techniques for Their Recovery from Agri-Food By-Products. Antioxidants 2022, 11, 2169. [Google Scholar] [CrossRef] [PubMed]
- Teixeira, R.F.; Benvenutti, L.; Burin, V.M.; Gomes, T.M.; Ferreira, S.R.S.; Zielinski, A.A.F. An eco-friendly pressure liquid extraction method to recover anthocyanins from broken black bean hulls. Innov. Food Sci. Emerg. Technol. 2021, 67, 102587. [Google Scholar] [CrossRef]
- Pomar, F.; Novo, M.; Masa, A. Varietal differences among the anthocyanin profiles of 50 red table grape cultivars studied by high performance liquid chromatography. J. Chromatogr. A. 2005, 1094, 34–41. [Google Scholar] [CrossRef]
- Ji, Y.; Fan, Y.; Liu, K.; Kong, D.; Lu, J. Thermo activated persulfate oxidation of antibiotic sulfamethoxazole and structurally related compounds. Water Res. 2015, 87, 1–9. [Google Scholar] [CrossRef]
- Khoo, H.E.; Azlan, A.; Tang, S.T.; Lim, S.M. Anthocyanidins and anthocyanins: Colored pigments as food, pharmaceutical ingredients, and the potential health benefits. Food Nutr. Res. 2017, 61, 1361779. [Google Scholar] [CrossRef]
- Bendokas, V.; Skemiene, K.; Trumbeckaite, S.; Stanys, V.; Passamonti, S.; Borutaite, V.; Liobikas, J. Anthocyanins: From plant pigments to health benefits at mitochondrial level. Crit. Rev. Food Sci. Nutr. 2020, 60, 3352–3365. [Google Scholar] [CrossRef]
- Nitteranon, V.; Kittiwongwattana, C.; Vuttipongchaikij, S.; Sakulkoo, J.; Srijakkoat, M.; Chokratin, P.; Harinasut, P.; Suputtitada, S.; Apisitwanich, S. Evaluations of the mutagenicity of a pigment extract from bulb culture of Hippeastrum reticulatum. Food Chem. Toxicol. 2014, 69, 237–243. [Google Scholar] [CrossRef]
- Berger, J.; Dillon, J.-C. Control of iron deficiency in developing countries. Cah. D’études Et De Rech. Francoph./St. 2002, 12, 22–30. [Google Scholar]
- Brown, S.; Houghton, J.; Hendry, G.; Scheer, H. Chlorophylls; CRC Press: Boca Raton, FL, USA, 1991. [Google Scholar]
- Tonucci, L.H.; Von Elbe, J.H. Kinetics of the formation of zinc complexes of chlorophyll derivatives. J. Agric. Food Chem. 1992, 40, 2341–2344. [Google Scholar] [CrossRef]
- Nonomura, Y.; Yamaguchi, M.; Hara, T.; Furuya, K.; Yoshioka, N.; Inoue, H. High-performance liquid chromatographic separation of iron (III) chlorophyllin. J. Chromatogr. A 1996, 721, 350–354. [Google Scholar] [CrossRef]
- Furuya, K.; Inoue, H.; Shirai, T. Determination of pheophytinatoiron (III) chlorides by reversed phase high performance liquid chromatography. Anal. Sci. 1987, 3, 353–357. [Google Scholar] [CrossRef]
- Britton, G. The Biochemistry of Natural Pigments; Cambridge University Press: Cambridge, UK, 1983. [Google Scholar]
- Schwartz, S.; Von Elbe, J. Kinetics of chlorophyll degradation to pyropheophytin in vegetables. J. Food Sci. 1983, 48, 1303–1306. [Google Scholar] [CrossRef]
- Solymosi, K.; Mysliwa-Kurdziel, B. Chlorophylls and their derivatives used in food industry and medicine. Mini Rev. Med. Chem. 2017, 17, 1194–1222. [Google Scholar] [CrossRef]
- Kang, Y.-R.; Park, J.; Jung, S.K.; Chang, Y.H. Synthesis, characterization, and functional properties of chlorophylls, pheophytins, and Zn-pheophytins. Food Chem. 2018, 245, 943–950. [Google Scholar] [CrossRef]
- Von Elbe, J.; Schwartz, S. Colorants. In Food Chemistry, 3rd ed. (or Fennema, ed.); Marcel Dekker, Inc.: New York, NY, USA, 1996. [Google Scholar]
- Reyes, T.F.; Chen, Y.; Fraser, R.Z.; Chan, T.; Li, X. Assessment of the potential allergenicity and toxicity of Pichia proteins in a novel leghemoglobin preparation. Regul. Toxicol. Pharmacol. 2021, 119, 104817. [Google Scholar] [CrossRef]
- Jun, H.-K.; Sarath, G.; Wagner, F.W. Detection and purification of modified leghemoglobins from soybean root nodules. Plant Sci. 1994, 100, 31–40. [Google Scholar] [CrossRef]
- Anderson, C.; Jensen, E.O.; Llewellyn, D.J.; Dennis, E.S.; Peacock, W.J. A new hemoglobin gene from soybean: A role for hemoglobin in all plants. Proc. Natl. Acad. Sci. USA 1996, 93, 5682–5687. [Google Scholar] [CrossRef]
- Kosmachevskaya, O.V.; Nasybullina, E.I.; Shumaev, K.B.; Topunov, A.F. Expressed soybean leghemoglobin: Effect on Escherichia coli at oxidative and nitrosative stress. Molecules 2021, 26, 7207. [Google Scholar] [CrossRef] [PubMed]
- Hargrove, M.S.; Barry, J.K.; Brucker, E.A.; Berry, M.B.; Phillips, G.N., Jr.; Olson, J.S.; Arredondo-Peter, R.; Dean, J.M.; Klucas, R.V.; Sarath, G. Characterization of recombinant soybean leghemoglobin a and apolar distal histidine mutants. J. Mol. Biol. 1997, 266, 1032–1042. [Google Scholar] [CrossRef] [PubMed]
- Bakhsh, A.; Lee, S.-J.; Lee, E.-Y.; Hwang, Y.-H.; Joo, S.-T. Evaluation of rheological and sensory characteristics of plant-based meat analog with comparison to beef and pork. Food Sci. Anim. Resour. 2021, 41, 983. [Google Scholar] [CrossRef] [PubMed]
- Basuki; Suyitno; Kristiawan, B. Absorbance and electrochemical properties of natural indigo dye. In AIP Conference Proceedings, Proceedings of the The 3rd International Conference on Industrial, Mechanical, Electrical, and Chemical Engineering, Surakarta, Indonesia, 13–14 September 2017; Universitas Sebelas Mare: Surakarta, Indonesia, 2017; Volume 1931, p. 030067-1-5. [Google Scholar]
- Singhee, D.; Sarkar, A. Colorimetric Measurement and Functional Analysis of Selective Natural Colorants Applicable for Food and Textile Products. Colorimetry 2022, 129–154. [Google Scholar]

| Treatment | |
|---|---|
| Sequence | |
| pBHA (1987 bp) | GAATTCAGCCAGCAAGACAGCGATATCACCTGTAAGTCGGAC GAATTCGGCGCTCTTCCGCTTCCTCGCTCACTGACTCGCTGCGCTCGGTCGTTCGGCTGCGGCGAGCGGTATCAGCTCACTCAAAG GCGGTAATACGGTTATCCACAGAATCAGGGGATAACGCAGGAAAGAACATGTGAG CAAAAGGCCAGCAAAAGGCCAGGAACCGTAAAAAGGCCGCGTTGCTGGCGTTTTTCCATAGGCTCCGCCCCCCTGACGAGCATC ACAAAAATCGACGCTCAAGTCAGAGGTGGCGAAACCCGACAGGACTATAAAGATAC CAGGCGTTTCCCCCTGGAAGCTCCCTCGTGCGCTCTCCTGTTCCGACCCTGCCGCTTACCGGATACCTGTCCGCCTTTCTCCCTTCG GGAAGCGTGGCGCTTTCTCATAGCTCACGCTGTAGGTATCTCAGTTCGGTG TAGGTCGTTCGCTCCAAGCTGGGCTGTGTGCACGAACCCCCCGTTCAGCCCGACCGCTGCGCCTTATCCGGTAACTATCGTCTTGA GTCCAACCCGGTAAGACACGACTTATCGCCACTGGCAGCAGCCACTGGTAACAGGATTAG CAGAGCGAGGTATGTAGGCGGTGCTACAGAGTTCTTGAAGTGGTGGCCTAACTACGGCTACACTAGAAGAACAGTATTTGGTATC TGCGCTCTGCTGAAGCCAGTTACCTTCGGAAAAAGAGTTGGTAGCTCTTGATCCGG CAAACAAACCACCGCTGGTAGCGGTGGTTTTTTTGTTTGCAAGCAGCAGATTACGCGCAGAAAAAAAGGATCTCAAGAAGATCCT TTGATCTTTTCTACGGGGTCTGACGCTCAGTGGAACGAAAACTCACGTTAAGGGATTTT GGTCATGAGATTATCAAAAAGGATCTTCACCTAGATCCTTTTAAATTAAAAATGAAGTTTTAAATCAATCTAAAGTATGAGTAAA CTTGGTCTGACAGTTACCAATGCTTAATCAGTGAGGCACCTATCTCAGCGATCTGTC TATTTCGTTCATCCATAGTTGCCTGACTCCCCGTCGTGTAGATAACTACGATACGGGAGGGCTTACCATCTGGCCCCAGTGCTGCA ATGATACCGCGAGACCCACGCTCACCGGCTCCAGATTTATCAGCAATAAACCAGCCAGCCG GAAGGGCCGAGCGCAGAAGTGGTCCTGCAACTTTATCCGCCTCCATCCAGTCTATTAATTGTTGCCGGGAAGCTAGAGTAAGTAG TTCGCCAGTTAATAGTTTGCGCAACGTTGTTGCCATTGCTACAGGCATCGTGGTGTCAC GCTCGTCGTTTGGTATGGCTTCATTCAGCTCCGGTTCCCAACGATCAAGGCGAGTTACATGATCCCCCATGTTGTGCAAAAAAGCG GTTAGCTCCTTCGGTCCTCCGATCGTTGTCAGAAGTAAGTTGGCCGCAGTGTTATCAC TCATGGTTATGGCAGCACTGCATAATTCTCTTACTGTCATGCCATCCGTAAGATGCTTTTCTGTGACTGGTGAGTACTCAACCAAGT CATTCTGAGAATAGTGTATGCGGCGACCGAGTTGCTCTTGCCCGGCGTCAATACGGGATAA TACCGCGCCACATAGCAGAACTTTAAAAGTGCTCATCATTGGAAAACGTTCTTCGGGGCGAAAACTCTCAAGGATCTTACCGCTG TTGAGATCCAGTTCGATGTAACCCACTCGTGCACCCAACTGATCTTCAG CATCTTTTACTTTCACCAGCGTTTCTGGGTGAGCAAAAACAGGAAGGCAAAATGCCGCAAAAAAGGGAATAAGGGCGACACGGA AATGTTGAATACTCATACTCTTCCTTTTTCAATATTATTGAA GCATTTATCAGGGTTATTGTCTCATGAGCGGATACATATTTGAATGTATTTAGAAAAATAAACAAATAGGGGTTCCGCGCACATTT CCCCGAAAAGTGCCACGTGA |
| LegH (528 bp) | CCATGGAAGCTTCATCATCATCATCATCACGCGGCCGCG GATCCGAATTCGTCGACAGATCTAGGCCTATGGGTGCTTTTACTGAAAAGCAAGAGGCTTTGGTTTCTTCTTCTTTTGAGGCTTTTA AGGCTAACATTCCACAATACTCTGTTGTTTTCTATACTTCTATTTTGGA GAAGGCTCCTGCTGCTAAAGATTTGTTTTCTTTCTTGTCTAACGGTTTGATCCATCTAATCCTAAGTTGACTGGTCATGCTGAAAAA TTGTTTGGTTTGGTTAGAGATTCTGCTGGTCAATTGAAGGCTAATGGTACTGTTGTT GCTGATGCTGCTTTGGGTTCTATTCACGCTCAAAAGGCTATTACTGATCCACAATTCGTTGTTGTTAAGGAGGCTTTGTTGAAAACT ATTAAGGAGGCTGTTGGAGATAAATGGTCTGATGAATTGTCCTCTGCTTGGGAAGTT GCTTACGATGAATTGGCTGCTGCTATTAAGAAGGCTTTTCACCACCACCACCACCACGCTGAGC |
| pBHA + LegH (2515 bp) | GAATTCAGCCAGCAAGACAGCGATCCATGGAAGCTTCATCATCATCATCATCAC GCGGCCGCGGATCCGAATTCGTCGACAGATCTAGGCCTATGGGTGCTTTTACTGAAAAGCAAGAGGCTTTGGTTTCTTCTTCTTTTGAGG CTTTTAAGGCTAACATTCCACAATACTCTGTTGTTTTCTATACTTCTATTTTGGA GAAGGCTCCTGCTGCTAAAGATTTGTTTTCTTTCTTGTCTAACGGTGTTGATCCATCTAATCCTAAGTTGACTGGTCATGCTGAAAAATTG TTTGGTTTGGTTAGAGATTCTGCTGGTCAATTGAAGGCTAATGGTACTGTTGTT GCTGATGCTGCTTTGGGTTCTATTCACGCTCAAAAGGCTATTACTGATCCACAATTCGTTGTTGTTAAGGAGGCTTTGTTGAAAACTATTA AGGAGGCTGTTGGAGATAAATGGTCTGATGAATTGTCCTCTGCTTGGGAAGTTGCTTAC GATGAATTGGCTGCTGCTATTAAGAAGGCTTTTCACCACCACCACCACCACGCTGA GCATCACCTGTAAGTCGGACGAATTCGGCGCTCTTCCGCTTCCTCGCTCAC TGACTCGCTGCGCTCGGTCGTTCGGCTGCGGCGAGCGGTATCAGCTCACTCAAAGGCGGTAATACGGTTATCCACAGAATCAGGGGATA ACGCAGGAAAGAACATGTGAGCAAAAGGCCAGCAAAAGGCCAGGAACCG TAAAAAGGCCGCGTTGCTGGCGTTTTTCCATAGGCTCCGCCCCCCTGACGAGCATCACAAAAATCGACGCTCAAGTCAGAGGTGGCGAA ACCCGACAGGACTATAAAGATAC CAGGCGTCTCCCTCGTGCGCTCTCCTGTTCCGACCCTGCCGCTTACCGGATACCTGTCCGCCTTTCTCCCTTCGGGAAGCGTGGCGCTTTC TCATAGCTCACGCTGTAGGTATCTCAGTTCGGTGTAGGTCGTTCGCTCCAA GCTGGGCTGTGTGCACGAACCCCCCGTTCAGCCCGACCGCTGCGCCTTATCCGGTAACTATCGTCTTGAGTCCAACCCGGTAAGACACGA CTTATCGCCACTGGCAGCAGCCACTGGTAACAGGATTAG CAGAGCGAGGTATGTAGGCGGTGCTACAGAGTTCTTGAAGTGGTGGCCTAACTACGGCTACACTAGAAGAACAGTATTTGGTATCTGCG CTCTGCTGAAGCCAGTTACCTTCGGAAAAAGAGTTGGTAGCTCTTGATCCGGCAAACAAAC CACCGCTGGTAGCGGTGGTTTTTTTGTTTGCAAGCAGCAGATTACGCGCAGAAAAAAAGGATCTCAAGAAGATCCTTTGATCTTTTCTAC GGGGTCTGACGCTCAGTGGAACGAAAACTCACGTTAAGGGATTTTGGTCATGAGAT TATCAAAAAGGATCTTCACCTAGATCCTTTTAAATTAAAAATGAAGTTTTAAATCAATCTAAAGTATATATGAGTAAACTTGGTCTGACA GTTACCAATGCTTAATCAGTGAGGCACCTATCTCAGCGATCTGTCTATTTCGTTCATCCA TAGTTGCCTGACTCCCCGTCGTGTAGATAACTACGATACGGGAGGGCTTACCATC |
| Color Indices | Myoglobin | Fe-pheophytin | Anthocyanin | Leghemoglobin |
|---|---|---|---|---|
| Lightness (L*) | 6.84 ± 0.01 c | 22.59 ± 0.05 a | 3.90 ± 0.01 d | 6.82 ± 0.01 c |
| Redness (a*) | 10.95 ± 0.01 b | 10.60 ± 0.03 c | 5.82 ± 0.01 d | 9.89 ± 0.01 b |
| Yellowness (b*) | 6.23 ± 0.06 c | 26.29 ± 0.04 b | 1.89 ± 0.02 d | 6.50 ± 0.05 c |
| Sample | Concentrations (%) | Pigments Weight (g) |
|---|---|---|
| Leghaemoglobin | 0.37 | 0.11 |
| Anthocyanin | 0.54 | 0.18 |
| Fe-chlorophyll | 1.00 | 0.30 |
| Myoglobin (control) | 1.76 | 0.53 |
Disclaimer/Publisher’s Note: The statements, opinions and data contained in all publications are solely those of the individual author(s) and contributor(s) and not of MDPI and/or the editor(s). MDPI and/or the editor(s) disclaim responsibility for any injury to people or property resulting from any ideas, methods, instructions or products referred to in the content. |
© 2023 by the authors. Licensee MDPI, Basel, Switzerland. This article is an open access article distributed under the terms and conditions of the Creative Commons Attribution (CC BY) license (https://creativecommons.org/licenses/by/4.0/).
Share and Cite
Bakhsh, A.; Cho, C.; Baritugo, K.A.; Kim, B.; Ullah, Q.; Rahman, A.; Park, S. Production and Analytical Aspects of Natural Pigments to Enhance Alternative Meat Product Color. Foods 2023, 12, 1281. https://doi.org/10.3390/foods12061281
Bakhsh A, Cho C, Baritugo KA, Kim B, Ullah Q, Rahman A, Park S. Production and Analytical Aspects of Natural Pigments to Enhance Alternative Meat Product Color. Foods. 2023; 12(6):1281. https://doi.org/10.3390/foods12061281
Chicago/Turabian StyleBakhsh, Allah, Changjun Cho, Kei Anne Baritugo, Bosung Kim, Qamar Ullah, Attaur Rahman, and Sungkwon Park. 2023. "Production and Analytical Aspects of Natural Pigments to Enhance Alternative Meat Product Color" Foods 12, no. 6: 1281. https://doi.org/10.3390/foods12061281
APA StyleBakhsh, A., Cho, C., Baritugo, K. A., Kim, B., Ullah, Q., Rahman, A., & Park, S. (2023). Production and Analytical Aspects of Natural Pigments to Enhance Alternative Meat Product Color. Foods, 12(6), 1281. https://doi.org/10.3390/foods12061281

